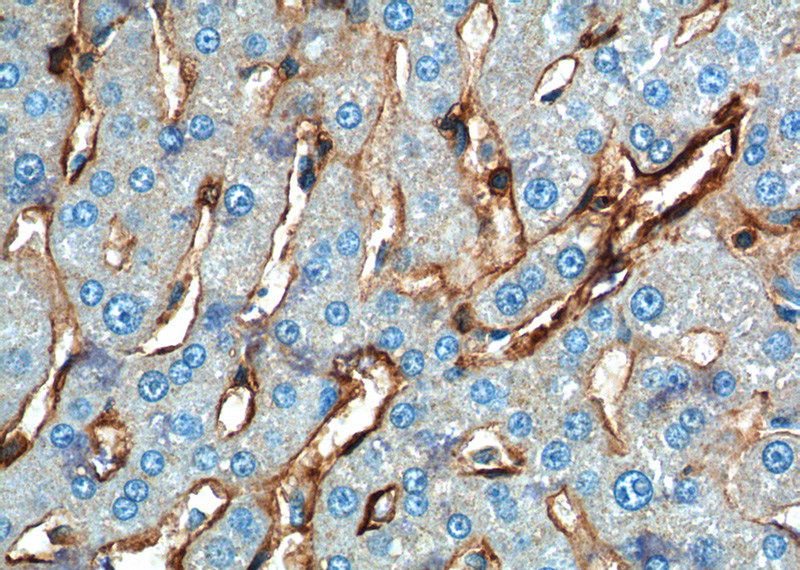

-
Product Name
Annexin A2 antibody
- Documents
-
Description
Annexin A2 Rabbit Polyclonal antibody. Positive IHC detected in human liver tissue, human colon cancer tissue, human oesophagus cancer tissue. Positive IF detected in HeLa cells, NIH/3T3 cells. Positive IP detected in HeLa cells. Positive WB detected in HeLa cells, K-562 cells, mouse placenta tissue, NIH/3T3 cells, rat uterus tissue. Observed molecular weight by Western-blot: 39 kDa
-
Tested applications
ELISA, IP, WB, IF, IHC
-
Species reactivity
Human, Mouse, Rat; other species not tested.
-
Alternative names
Annexin 2 antibody; annexin A2 antibody; Annexin II antibody; ANX2 antibody; ANX2L4 antibody; ANXA2 antibody; CAL1H antibody; Calpactin 1 heavy chain antibody; Calpactin I heavy chain antibody; Chromobindin 8 antibody; LIP2 antibody; LipOCortin II antibody; LPC2 antibody; LPC2D antibody; P36 antibody; PAP IV antibody; Protein I antibody
-
Isotype
Rabbit IgG
-
Preparation
This antibody was obtained by immunization of Annexin A2 recombinant protein (Accession Number: XM_017022090). Purification method: Antigen affinity purified.
-
Clonality
Polyclonal
-
Formulation
PBS with 0.1% sodium azide and 50% glycerol pH 7.3.
-
Storage instructions
Store at -20℃. DO NOT ALIQUOT
-
Applications
Recommended Dilution:
WB: 1:1000-1:10000
IP: 1:200-1:2000
IHC: 1:50-1:500
IF: 1:50-1:500
-
Validations

HeLa cells were subjected to SDS PAGE followed by western blot with Catalog No:108093(Annexin A2 Antibody) at dilution of 1:2000

Immunohistochemistry of paraffin-embedded human liver tissue slide using Catalog No:108093(Annexin A2 Antibody) at dilution of 1:200 (under 10x lens).
Immunohistochemistry of paraffin-embedded human liver tissue slide using Catalog No:108093(Annexin A2 Antibody) at dilution of 1:200 (under 40x lens).

Immunofluorescent analysis of (-20oc Ethanol) fixed HeLa cells using Catalog No:108093(Annexin A2 Antibody) at dilution of 1:100 and Alexa Fluor 488-congugated AffiniPure Goat Anti-Rabbit IgG(H+L)

IP Result of anti-ANXA2 (IP:Catalog No:108093, 3ug; Detection:Catalog No:108093 1:500) with HeLa cells lysate 3000ug.
-
Background
Annexin A2 (ANXA2), also named Annexin-2 or Lipocortin II, is a Ca2+ binding protein that is up-regulated in virally transformed cell lines and human tumors. This calcium-regulated membrane-binding protein, whose affinity for calcium is greatly enhanced by anionic phospholipids, may cross-link plasma membrane phospholipids with actin and the cytoskeleton and be involved with exocytosis. Heat-stress response may also involve Annexin-2.
-
References
- Zhuang H, Tan M, Liu J. Human epididymis protein 4 in association with Annexin II promotes invasion and metastasis of ovarian cancer cells. Molecular cancer. 13:243. 2014.
- Li J, Guo D, Huang L. The interaction between host Annexin A2 and viral Nsp9 is beneficial for replication of porcine reproductive and respiratory syndrome virus. Virus research. 189:106-13. 2014.
- Lu CM, Lin JJ, Huang HH. A panel of tumor markers, calreticulin, annexin A2, and annexin A3 in upper tract urothelial carcinoma identified by proteomic and immunological analysis. BMC cancer. 14:363. 2014.
- Zhuang H, Tan M, Liu J. The expression of annexin II and Lewis y antigen in ovarian epithelial tumors and the correlation between them. Tumour biology : the journal of the International Society for Oncodevelopmental Biology and Medicine. 36(4):2343-9. 2015.
- Chen P, Yan H, Tian Y. Annexin A2 as a target endothelial cell membrane autoantigen in Behçet's disease. Scientific reports. 5:8162. 2015.
- Dai J, Zhan C, Xu W. Nicotine elevates sperm motility and induces Pfn1 promoter hypomethylation in mouse testis. Andrology. 3(5):967-78. 2015.
- Renner B, Tong HH, Laskowski J. Annexin A2 Enhances Complement Activation by Inhibiting Factor H. Journal of immunology (Baltimore, Md. : 1950). 196(3):1355-65. 2016.
- Minamide LS, Maiti S, Boyle JA. Isolation and characterization of cytoplasmic cofilin-actin rods. The Journal of biological chemistry. 285(8):5450-60. 2010.
Related Products / Services
Please note: All products are "FOR RESEARCH USE ONLY AND ARE NOT INTENDED FOR DIAGNOSTIC OR THERAPEUTIC USE"
